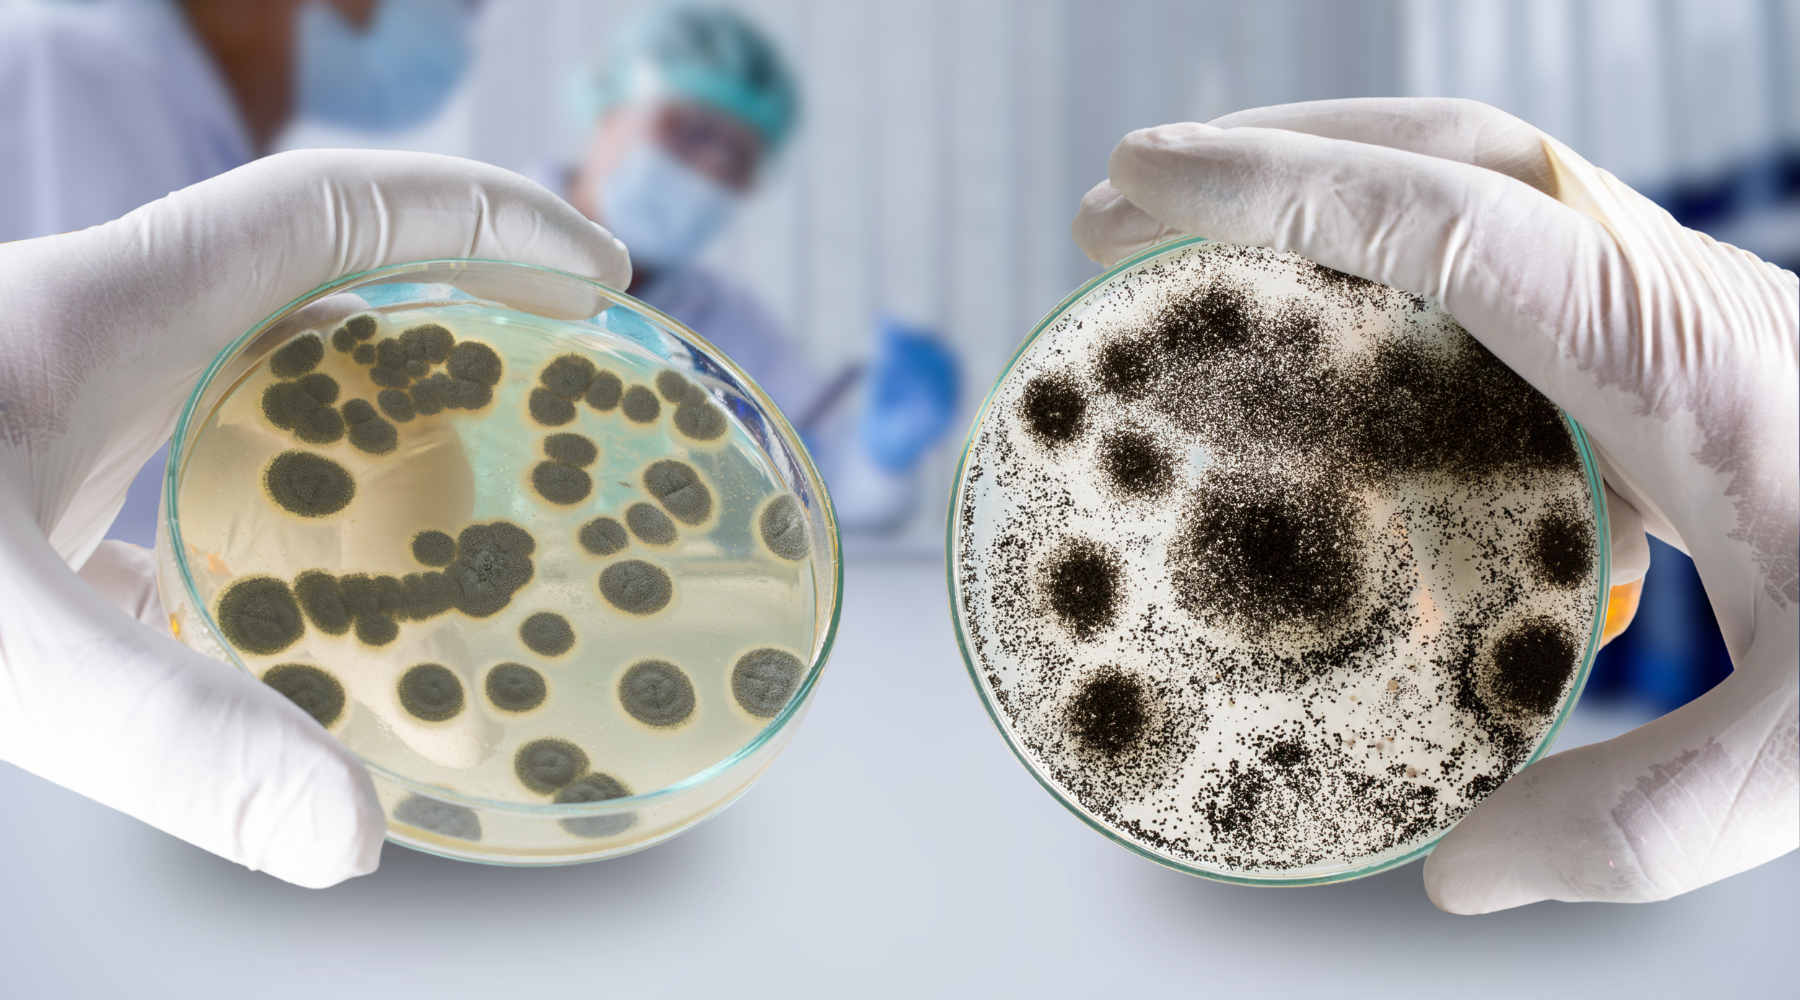

News
-

, by Tatianna Gerard Do Thicker Bin Liners Reduce or Increase Plastic Waste?
When it comes to sustainability, it’s easy to assume that thinner is always better. A thinner bin liner must use less plastic — and less...
-

, by Tatianna Gerard What Repels Wasps? Natural and Practical Ways to Keep Them Away
Wasps are a common sight around homes, especially when the weather warms up and people start spending more time outdoors. They tend to show up...
-

, by Tatianna Gerard Australians Want to Buy Local — So Why Is It Still So Hard?
Australians take pride in supporting local — whether it’s choosing homegrown produce, Aussie-made skincare, or locally manufactured household products. But according to new data from...
-

, by Tatianna Gerard How to Tell If A Product is Truly Australian Made
We’ve all been there—you’re standing in the shop, scanning the shelves, and something catches your eye. The label has a kangaroo, maybe a splash of...
-

, by Tatianna Gerard Is There Mould Hiding Behind Your Paint? Why Painting Over It Doesn’t Work
You’ve scrubbed the mould spots off your bathroom wall, given it a fresh coat of paint, and everything looks clean again — for now. But...
-

, by Tatianna Gerard The Surprising Reason You Have Mould Around Your Windows (It’s Not Just Condensation)
If you’ve ever noticed mould creeping around your windows or doors, your first thought was probably condensation. It makes sense—warm indoor air hits cold glass,...
-

, by Tatianna Gerard 6 Pregnancy-Safe Products We Recommend
With so much to think about — from what you eat to what you apply on your skin and use around your home — it’s...
-

, by Tatianna Gerard Still Using Mothballs? Here’s Why It’s Time to Stop
You’ve probably seen them before — those white, chalky balls tucked into old wardrobes or boxes of clothes. Maybe your grandparents used them. Maybe you...
-

, by Tatianna Gerard How to Get Rid of Fruit Flies Naturally: Easy Solutions That Really Work
You’ve just cleaned the kitchen, only to spot tiny flies hovering around your fruit bowl, sink, or compost bin. Fruit flies are one of the...
-

, by Tatianna Gerard Eco-Friendly Bin Liners: A Sustainable Solution for Reducing Plastic Waste
Plastic waste has become one of the most pressing environmental issues of our time, and Australia is no exception. Each year, the country consumes a...
-

, by Tatianna Gerard Winter vs. Summer Mould: What’s the Difference
Mould can be a problem at any time of year, but how and where it shows up in your home often depends on the season....
-

, by Tatianna Gerard Keep Insects Away Naturally: Here Are the Essential Oils That Work
Insects are an inevitable part of life, but that doesn’t mean they have to invade your home or spoil your outdoor plans. From mosquitoes and...